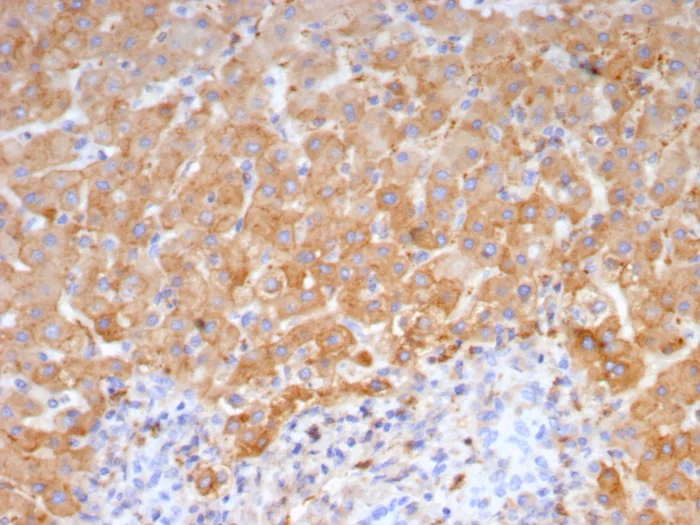

Formalin-fixed, paraffin-embedded human liver stained with Haptoglobin Mouse Monoclonal Antibody (HP/4815). HIER: Tris/EDTA, pH9.0, 45min. 2°C: HRP-polymer, 30min. DAB, 5min.
Formalin-fixed, paraffin-embedded human hepatocellular carcinoma stained with Haptoglobin Mouse Monoclonal Antibody (HP/4815). HIER: Tris/EDTA, pH9.0, 45min. 2°C: HRP-polymer, 30min. DAB, 5min.

SDS-PAGE Analysis of Purified Haptoglobin Mouse Monoclonal Antibody (HP/4815). Confirmation of Purity and Integrity of Antibody.

Analysis of Protein Array containing more than 19,000 full-length human proteins using Haptoglobin-Monospecific Mouse Monoclonal Antibody (HP/4815) Z- and S- Score: The Z-score represents the strength of a signal that a monoclonal antibody (MAb) (in combination with a fluorescently-tagged anti-IgG secondary antibody) produces when binding to a particular protein on the HuProtTM array. Z-scores are described in units of standard deviations (SD's) above the mean value of all signals generated on that array. If targets on HuProtTM are arranged in descending order of the Z-score, the S-score is the difference (also in units of SD's) between the Z-score. S-score therefore represents the relative target specificity of a MAb to its intended target. A MAb is considered to specific to its intended target, if the MAb has an S-score of at least 2.5. For example, if a MAb binds to protein X with a Z-score of 43 and to protein Y with a Z-score of 14, then the S-score for the binding of that MAb to protein X is equal to 29.
Haptoglobin (Hp) is a blood plasma protein that functions to bind free Hemoglobin that has been released from erythrocytes, thereby inhibiting its oxidative activity. During this process, Haptoglobin sequesters the iron within Hemoglobin, preventing iron-utilizing bacteria from benefitting from hemolysis. This function suggests that Haptoglobin concentrations may increase in response to inflammation. The resulting Haptoglobin-Hemoglobin complex is then removed by the reticulo-endothelial system. Due to cleavage of a common precursor protein during protein synthesis, Haptoglobin consists of two a and two b chains, connected by disulfide bridges. In human, Haptoglobin exists in two allelic forms designated Haptoglobin 1 (Hp1) and Haptoglobin 2 (Hp2), where Hp2 is the result of a partial Hp1 gene duplication. There are three known phenotypes of human Haptoglobin: Hp1-1, Hp2-1 and Hp2-2, which may be associated with diabetes and cardiovascular disease pathology and a susceptibility to Parkinson s and Crohn s disease. Haptoglobin levels are useful in diagnosing hemolytic anemia, the abnormal breakdown of red blood cells. Haptoglobin is expressed in mammalian hepatocytes as well as other tissues such as skin, lung and kidney.
There are no reviews yet.